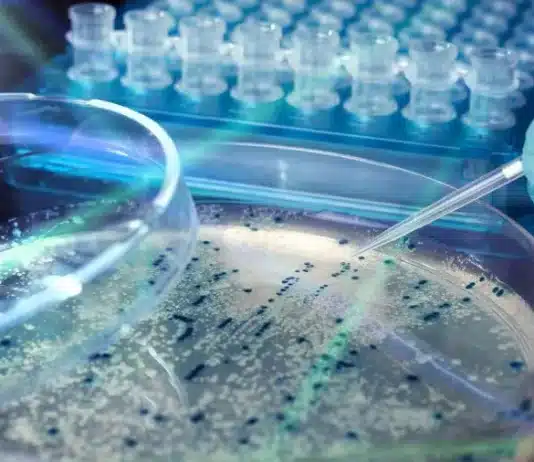
As human extinction draws nearer this may be the only saving solution

One has to have their eyes well and truly focused and alert these days. Like buying a vegetarian pizza for instance.
What do we have...
The following is extremely disturbing. It reveals sexual violence on a huge scale taking place at the tea plantations in Kenya.
Many major supermarkets...
New app to help people eat the right portions to get to 5 a dayWhilst most people are aware of the 5-a-day message, studies...
The consequences of indulging will become more apparent when the holiday party season begins. Here are some depressing statistics about hangovers and strategies you...
I believe this is the most important environmental technology ever developed. It might be all that now stands between us and Earth systems collapse.
So...
Livestock farming is responsible for more greenhouse gas pollution than all the world’s transport. Yet governments won’t touch it.
There are just two actions needed...
The transition from the EU’s Basic Payment Scheme is likely to result in a big loss to the Dorset economy, says NFU county advisor...
Cucumbers contain most of the vitamins you need every day, just one cucumber contains Vitamin B1, Vitamin B2, Vitamin B3, Vitamin B5, Vitamin B6,...
No attempt to really help the UK public. Just enable them to die earlier.
All the things they could do but won't because it...
Tesco, M&S, Waitrose and Sainsbury's are recalling a number of chicken products due to fears of salmonella.
Tesco are withdrawing 14 items from sale, including...